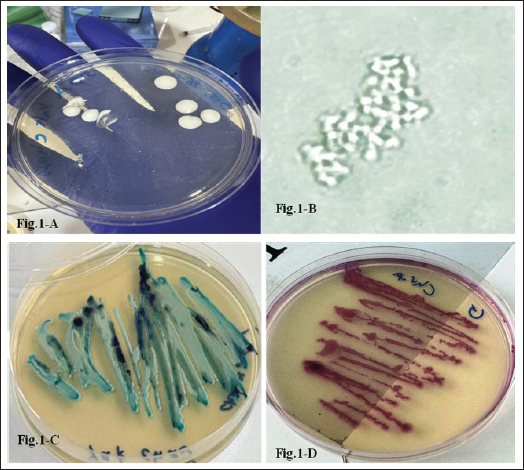

| Research Article | ||
Open Vet. J.. 2026; 16(2): 1012-1026 Open Veterinary Journal, (2026), Vol. 16(2): 1012-1026 Research Article Investigating the human–animal interface: Clinical and molecular features of oral Candida spp. in cat ownersMoamen Amer Ali1 and Ali Ibrahim Ali Al-Ezzy2*1Department of Medicine, College of Veterinary Medicine, University of Diyala, Baqubah, Iraq 2Department of Pathology, College of Veterinary Medicine, University of Diyala, Baqubah, Iraq *Corresponding Author: Ali Ibrahim Ali Al-Ezzy. Department of Pathology, College of Veterinary Medicine,University of Diyala, Baqubah, Iraq. Email: ali.ib [at] uodiyala.edu.iq Submitted: 21/07/2025 Revised: 15/01/2026 Accepted: 31/01/2026 Published: 28/02/2026 © 2026 Open Veterinary Journal
ABSTRACTBackground: Candida albicans is a ubiquitous commensal fungus and is capable of transitioning from commensalism to infection. Aim: To isolate and identify Candida spp. from oral swabs of domestic cats. Detection of virulence factors, agglutinin-like sequence agglutinin-like sequence 1 (ALS), and Candidalysin (ECE1) genes exploration of the possible relationship between Candida and potential risk factors in cat owners. Methods: A total of 119 oral swabs were collected from cat owners and streaked directly on Sabouraud’s dextrose and chrome agars. Confirmation was performed by testing the isolates using the Vitek 2 compact system and conventional polymerase chain reaction (PCR) using primers specific to the ITS4 and ITS5 regions. ALS and ECE1 genes were detected using conventional PCR. Results: The total number of Candida spp. isolated from the oral cavity of cat owners was 10/119 (8.40%). Correlations were reported between the isolation of Candida from the oral cavity and age group; use of oral antibiotic drops; diabetes mellitus; oral lesions; and vitamin D3 deficiency (p value < 0.001). No significant correlation was reported between sex, season, smoking habit, denture wearing, steroid inhalation, immune suppression, and Candida isolation from the oral cavity of cat owners. ASL1 and ECE1 were detected in 100% of C. albicans isolated from the oral cavity of cat owners. Conclusion: This study reveals a low prevalence but high pathogenic potential of oral C. albicans in domestic cat owners, as evidenced by the universal presence of major virulence genes (ALS1, ECE1). Older age, antibiotic drops, Diabetes miletus, oral lesions, and vitamin D3 deficiency were associated with the risk of colonization. The commonly suspected risk factors showed no association. The universal presence of ALS1 and ECE1 highlights the pathogenic threat posed by these yeasts. Keywords: Candida, Cat owners, Oral mucosa, Virulence, Zoonoses. IntroductionCandida albicans is a ubiquitous commensal fungus constituting a significant component of the human mycobiota, persistently colonizing the oral, gastrointestinal, and vaginal mucosa in a substantial proportion of the healthy population (Lemberg et al., 2022). However, C. albicans also exhibits pathobiont behavior, capable of transitioning from commensalism to infection. These infections range from superficial mucocutaneous manifestations (e.g., oropharyngeal candidiasis and vulvovaginal candidiasis) to severe, disseminated, and often life-threatening systemic candidiasis, particularly in healthcare settings (Calderone and Clancy, 2012). The oral cavity hosts multiple Candida species, including C. albicans, C. glabratas, C. krusei, C. parapsilosis, C. pseudotropicalis, C. stellatoidea, and C. tropicalis (Jafar, 2021). In immunocompetent and immunocompromised hosts, oral candidiasis can present as several distinct conditions, such as hyperplastic candidiasis, atrophic (denture) candidiasis, pseudomembranous candidiasis (thrush), linear gingival erythema, median rhomboid glossitis, and angular cheilitis Sharon and Fazel, 2010; Bhosale et al., 2023). This infection exhibits a broad clinical spectrum: superficial candidiasis (the most frequent form) involves mild acute presentations, whereas disseminated candidiasis (predominantly in immunodeficient states) can be fatal (Ahmad et al., 2020). The disruption of normal host immunity allows C. albicans to cause thrush. Yeast proliferates on the oral mucosa, inducing the desquamation of epithelial cells and accumulation of keratin, bacteria, and necrotic debris. This debris coalesces into a closely adherent pseudomembrane. Although uncommon, underlying mucosal involvement can include extensive edema, ulceration, and necrosis (Hashemi et al., 2019) A critical determinant of susceptibility identified across multiple studies is the host immune status. Systematic analyses of patient cohorts consistently show that C. albicans infections occur predominantly in immunocompromised individuals (Li et al., 2017). Furthermore, robust genetic and clinical evidence specifically links the development of recurrent or persistent mucocutaneous candidiasis to defects in adaptive cellular immunity, particularly impairments in T cell function and the IL-17 signaling axis, whether acquired or inherited gain-of-function mutations, AIRE deficiency, IL-17 receptor/ligand deficiencies (Li et al., 2017). The equilibrium between harmless colonization and pathogenic invasion is governed by a complex interplay of host defenses and microbial factors. While intact host immunity, especially involving T cells and IL-17 responses, is unequivocally essential for containing fungal overgrowth and preventing tissue invasion (Li et al., 2017), the intrinsic virulence potential of the colonizing C. albicans isolate is also a major contributing factor to disease outcome. Candida albicans exhibits substantial intraspecies genetic diversity that translates into measurable phenotypic heterogeneity among clinical isolates, leading to variations in adhesion capacity, morphogenetic switching (yeast-to-hyphae transition), stress tolerance, secreted hydrolase activity, biofilm formation, and metabolic adaptability (Ropars et al., 2018). Candida spp., particularly C. albicans, colonize the oral mucosae in 30%–60% of healthy humans (Marcos-Arias et al., 2011; Dąbrowska et al., 2018) and 10% of cats (Nikaein et al., 2023) Although most human candidiasis originates from endogenous flora, zoonotic transmission from pets, such as cats, remains possible due to close cohabitation behaviors (e.g., face-licking), which present potential transmission routes Vourc’h et al., 2022). Phylogenetic analysis of C. albicans isolates from various animal and human origins failed to find species-specific lineages, although the nearest-neighbor analysis did show some level of separation between human and animal isolates (Edelmann et al., 2005). Although the barriers to cross-species transmission were likely higher than those required for human-to-human transmission, they did not appear to be insurmountable based on our findings. Additional studies of patients and their pet isolates are needed to provide an approximation of how commonly animals are infected through human-to-animal (or animal-to-human) contact (McManus and Coleman, 2014). Animals must be considered as potential sources of Candida to human beings where humans are immunosuppressed (Edelmann et al., 2005). The current study aimed to isolate and identify Candida spp. from owners of domestic cats. Detection of the ability of biofilm formation and hemolysin (Candidalysin) production by conventional polymerase chain reaction (PCR). Finally, the possible relationship between the presence of Candida and potential risk factors in cat owners was described and explored. Materials and MethodsStudy areaThis study was conducted in veterinary clinics in Suleimani Governorate. Collection of the samplesThis cross-sectional study was conducted from 10, September 2024 until 25, June 2025. The study included 119 owners of domestic cats. Oral swabs were collected and transferred to the mycology laboratory at the College of Veterinary Medicine, University of Suleimani. Two questions were submitted to the participants, the first related to owners and the second related to cats. Inclusion criteria for cat ownersa) The participant must be the primary caregiver and decision-maker for at least one domestic cat. b) The participant has owned the cat for a minimum of [e.g., 3 months] to ensure stable ownership. c) The participant should be willing and able to provide informed consent and comply with the study protocol. Oral swab culture on Sabouraud’s Dextrose agar and Chrom agar CandidaDirect microscopical examinationA sample from the swab was transferred to a clean glass slide, covered with a coverslip, and briefly passed through a flame for heat fixation two to three times. The prepared slide was then examined under light microscopy using 10X and 40X objectives to identify yeasts and pseudohyphae (Hall, 2013). A second slide was heat-fixed and Gram-stained to visualize yeast cells (Carroll and Pfaller, 2024). Indirect examinationSwabs were inoculated onto Sabouraud dextrose agar (SDA) plates (Himedia, Mumbai, India) containing 0.050 g/1,000 g of chloramphenicol and incubated at 37°C for 24–48 hours (Musleh and Al-Saadi, 2022). Isolation and purificationThe individual colonies from all SDA-cultured samples were aseptically isolated and purified (Marsh and Martin, 2009). IdentificationMorphological characteristicsColor, shape, texture, diameter, elevation, and odor of colonies growing on SDA and Chrom agar were examined (Ellis et al., 2007). Microscopic characteristicsA portion of the colony was aseptically transferred with an inoculation loop, emulsified in a drop of lactophenol cotton blue stain, and spread onto a sterile glass slide. A coverslip was applied, and the preparation was examined under light microscopy using 10X and 40X objectives to observe yeast cells, pseudohyphae, and blastoconidia (Ellis et al., 2007; Al-Khalidi et al., 2018) second smear was prepared on a separate sterile slide, heat-fixed by passing through a flame, stained using the Gram stain technique, and examined microscopically for germ tube formation (Ellis et al., 2007). Biochemical testsPure 24-hour yeast colonies grown on SDA were streaked onto chromogenic agar Candida plates using a sterile inoculating loop according to (Musleh and Al-Saadi, 2022). The germ tube test was performed according to (Ellis et al., 2007). Identification of Candida spp. using the Vitek 2 compact systemYeast was identified using the automated VITEK 2 system (bioMérieux, France). Purified isolates presumptively identified as Candida were processed according to the manufacturer’s specifications. Briefly, isolated colonies were emulsified in 0.45% sterile saline to achieve turbidity equivalent to a 2.0 McFarland standard. The suspension was used to inoculate a VITEK 2 YST identification card (Kaur et al., 2016). PCR-based molecular methodsDeoxyribonucleic acid (DNA) extractionDNA was extracted from Candida isolates using the Wizard Genomic DNA Purification Kit (Promega, USA) according to the manufacturer’s protocol. The extracted DNA was quantified using Qubit 4.0 with a sensitivity of detection 10–100 pg/µl. The assay was performed at room temperature, and the signal was stable for 3 hours. Common contaminants, such as salts, free nucleotides, solvents, detergents, or proteins, are well tolerated in the assay. Materials used for thermal cyclingPrimers selection and identification of Candida, universal primers ITS4, ITS5, agglutinin-like sequence 1 (ALS1) gene and Candidalysin (ECE1) gene Candidalysin gene according to the following: I. Universal primers ITS4, forward primer510bp., (5`TCCTCCGCTTATTGATATGC3`); PCR conditions: initial denaturation at 95°C for 5 minutes, followed by 35 cycles of denaturation at 95°C for 45 seconds, annealing at 57°C for 1 minute, extension at 72°C for 1 minute, and final elongation at 72°C for 7 minutes. Final incubation at 4°C. After the program was completed, the PCR products were loaded in 2% agarose gel, and the gel was run for 45 minutes at 100 V, then illuminated by a UV Transilluminator at 320 nm and photographed by a digital camera (White et al., 1990). II. Universal primers TS5, reverse primer, 721 bp, (5`GGAAGTAAAAGTGCTAACAAGG3`) PCR conditions according to (White et al., 1990): initial denaturation at 95°C for 5 minutes, followed by 35 cycles of denaturation at 95°C for 45 seconds, annealing at 57°C for 1 minute, extension at 72°C for 1 minute, and final elongation at 72°C for 7 minutes. Final incubation at 4°C. After the program was completed, the PCR products were loaded in 2% agarose gel, and the gel was run for 45 minutes at 100 V, then illuminated by a UV Transilluminator at 320 nm and photographed by a digital camera. Agglutinin-like sequence 1 (ALS1) gene: Forward primer /GACTAGGAACAACAAATACCAGA ; Reverse primer /CCAGAAGAAACAGCAGGTGA; size of product 318 bp. PCR conditions were as follows (Inci et al., 2013): initial denaturation at 94°C for 2 minutes, followed by 1 cycle of denaturation at 94°C for 4 minutes, annealing at 52°C for 60 seconds for 35 cycles, and extension at 72°C for 2 minutes, and the last elongation stage at 72 °C for 5 minutes. Final incubation at 4°C. After the program was completed, the PCR products were loaded in 2% agarose gel, and the gel was run for 45 minutes at 100 V, then illuminated by a UV Transilluminator at 320 nm and photographed by a digital camera. III. Candidalysin gene: forward primer /AGCTGTTGACACAGCCATGA, reverse primer /TCTGAAACAATTTGAGCAGCA; size of product 435 bp; PCR conditions according to (AL-Rubaie and Al-Qaysi, 2024): initial denaturation step 1 (at 94°C 5, minutes 1), then denaturation step 2 (at 94°C for 30 seconds), followed by 35 cycles, annealing step (at 58°C for 40 seconds), and final extension (at 72°C for 5 minutes). PCR products of the ECE1 gene were visualized on 2% agarose gel by dissolving 2 g of agarose in 100 ml. Electrophoresis was performed for 60 minutes at 70 V, and the bands that appeared on the gel were detected under a UV transilluminator at 302 nm, compared with ladder size. The PCR working solutionThis step was carried out by adding 12.5f µl from one Taq (NEB®) master mix, 3 µl of DNA sample, 1 µl from each primer,7.5 µl from nuclease-free water (New England Biolabs, 2024) under the optimum PCR conditions shown in Table 1 for the detection of CandidaECE1, and ALS1 genes. Gel electrophoresis protocolPreparation of 1X Tris-Acetate-EDTA (TAE) bufferTwo hundred milliliters of TAE buffer 50x was diluted to 10X by taking 200 ml of 50X TAE and adding to 800 ml of deionized distilled water. This 10X buffer was re-diluted to 1X (working concentration) by adding 100 ml of this buffer to 900 ml of deionized distilled water (Alkhuwailidy and Alrufae, 2022; Hadi et al., 2025a). Preparation of 2% agarose gel and loading of samples into the gelThe 1x TAE buffer is used as the solvent to dissolve agarose powder when making the gel. The same 1x TAE buffer is then used to fill the electrophoresis chamber to ensure uniform electrical conductivity and pH. To prepare a 2% agarose gel, weigh 2 g of agarose powder for every 100 ml of 1X running buffer (TAE or TBE), mix in a flask, and heat in the microwave until dissolved (swirling to prevent boil-over). Then, cool slightly, add DNA stain (ethidium bromide), and then pour into a taped casting tray with a comb and let it solidify. Ten microliters of PCR product and DNA ladder have been loaded into the gel wells. The power supply voltage was fixed at 80 V for 80 minutes. At the end of the run, gel documentation with a high-resolution camera was used to capture images and analyze the bands (Alkhuwailidy and Alrufae, 2022; Hadi et al., 2025b). Statistical analysisThe results were analyzed using Statistical Package for Social Scientists (SPSS version 18.0) (Al-Khalidi et al., 2020). The groups were determined using the chi-square test, and p-values of0.05 were considered significant when p < 0.05 (Al-Ezzy et al., 2016; Al-Ezzy, 2018). Correlations were determined using Pearson’s correlation coefficient (Hameed et al., 2024; Hameed and Al-Ezzy, 2024). Ethical approvalThis research was performed in accordance with the guidelines of the Helsinki Declaration. All cat owners signed an informed consent and agreed to participate in the present study. This agreement was confirmed by the ethics committee of the Pathology Department, College of Veterinary Medicine, University of Diyala, Iraq (UOD-CVM-patho. Dep. Issue No. 25/202 June 2024). ResultsIsolation and identification of Candida spp. in the oral cavity of cat ownersTable 1 and Figure 1 show the frequency of Candida species isolated from cat owners according to morphological features on chrome agar, SDA, and Viteck 2 compact system. The total number of isolated Candida spp. was 10/119 (approximately 8.40%). All Candida-positive samples were subjected to a confirmatory step by conventional PCR using ITS4 and ITS5. A length of 510 bp for ITS4 and 721 bp for ITS5 was guaranteed to be Candida, as shown in Figure 2. Table 1. Morphological identification of Candida species isolated from the oral cavity of cat owners.
Possible risk factors associated with C. albicans among cats and their ownersAs shown in Table 2, a significant difference was reported between the age groups infected with Candida spp. (p value < 0.001). A significant inverse correlation was reported between age group and isolation of Candida spp. (p value < 0.001). No significant difference was reported between sex and Candida isolation (p=0.528). No significant correlation was reported between sex and Candida isolation. From the oral cavity of cat owners (p=0.535). No significant difference (p=0.065) or correlation (p=0.275) was reported between economic status and Candida spp. isolation from the oral cavity of the cat owners. No significant difference (p=0.277) or correlation (p=0.307) was reported between employment and Candida spp. isolation from the oral cavity of the cat owners. Significant differences and inverse correlations were reported between vitamin D3 deficiency and Candida spp. isolation (p value=0.006). Significant differences (p=0.005) were reported between seasons in the isolation of Candida from the oral cavity of cat owners. No significant correlation (p=0.507) was reported between season and the isolation of Candida spp. from the oral cavity of the cat owners. No significant difference was reported among smokers and nonsmokers in the isolation of Candida spp. from the oral cavity (p=0.562). No significant correlation (p=0.496) was reported between smoking habit and Candida spp. isolation from the oral cavity of the cat owners. As shown in Table 3, there was a significant difference (p=0.001) in the isolation of Candida from the oral cavity of cat owners who were administering antibiotics and those who were not. A significant negative correlation (p value < 0.001) was reported between the use of oral antibiotic drops and the isolation of Candida spp. from the oral cavity of the cat owners. No significant difference was observed between those wearing dentures and those not wearing dentures in the isolation of Candida spp. (p=0.714). No correlations (p=0.992) were reported between wearing dentures and the isolation of Candida spp. from the oral cavity. A significant difference (p=0.001) was reported between those with and without Diabetes miletus (DM) in the isolation of Candida spp. from the oral cavity of the cat owners. An inverse correlation (p=0.001) was reported between DM and Candida spp. isolation. From the oral cavity of the cat owners. No significant difference (p=0.377) or correlation (p=0.287) was reported between the inhalation of steroids and the isolation of Candida spp. from the oral cavity of the cat owners. A significant difference (p=0.001) was observed in the isolation of Candida species based on oral brushing habits. Furthermore, a significant negative correlation (p < 0.001) was found between the frequency of tooth brushing and the isolation of Candida species from the cat owners’ oral cavity.
Fig. 1. (A). Macroscopic appearance of Candida swabbed from the oral cavity of a cat owner at 37 °C on Sabouraud's dextrose agar for 48 hours. Colonies appear typically as creamy white to yellowish-white, smooth, and pasty. (B). Microscopic appearance of germ tube formed by Candida swabbed from the oral cavity of a cat owner, incubated at 37 °C for 6 hours. (C). Macroscopic appearance of Candida albicans swabbed from the oral cavity of a cat owner at 37 °C on chrome agar for 48 hours. Candida albicans typically forms distinctive green or blue-green colonies. (D). Macroscopic appearance of candida swabbed from the oral cavity of a cat owner at 37 °C on chrome agar for 48 hours. Candida glabrata usually appears as mauve (pinkish-purple) colonies.
Fig .2. DNA products of Candida spp. generated using the universal primers ITS4 (510 bp) line S2 and S7 and ITS5 (721 bp) gene primers line S1 and S6 stained with ethidium bromide. M: Molecular marker (100 bp); lanes 1–8, Candida spp. Oral diseases and isolation of Candida from the oral cavities of cat ownersAs presented in Table 4, a statistically significant difference was observed in the prevalence of Candida isolation between individuals with and without oral lesions (p < 0.001). Furthermore, a significant inverse correlation was identified between the presence of oral lesions and the isolation of Candida species from the oral cavity of domestic cat owners (p < 0.001). Table 2. Demographics as a possible risk factor of Candida infection among cat owners.
Table 3. Possible risk factors associated with Candida colonization among cat owners.
Table 4. Oral diseases associated with Candida infection among domestic cat owners.
Fig. 3. DNA products of the candidalysin gene generated through the ECE1 gene (435 bp) bands of sample (1–4). The presence of bands at approximately 435 bp indicates the successful amplification of a specific region or the entire gene sequence for ECE1 in samples 1–4. DNA products of agglutinin-like sequence 1 (ALS1) gene (318 bp) primers, stained with ethidium bromide. The presence of bands at approximately 318 base pairs (bp) indicates the successful amplification of a specific region or the entire gene sequence for ALS1 in samples 1–4. L: Molecular marker. Detection of agglutinin-like sequence 1 (ALS1) and Candidalysin genes (ECE1) in C. albicans isolated from the oral cavity of cat ownersAs indicated in Table 5, both the ALS1 gene and the ECE1 gene (encoding the Candidalysin toxin) were detected in the oral cavity of feline caregivers. As further demonstrated in Figure 3, these virulence genes were present in all isolates examined—specifically, 4 out of 4 (100%) of the C. albicans samples harbored both ALS1 and ECE1, indicating a consistent expression of these pathogenic genes. Table 5. Frequency of PCR-based detection of ASL1 and ECE1 produced by C. albicans isolated from the oral cavity of cat owners.
DiscussionIsolation frequencyThe current study demonstrated a relatively low prevalence of oral Candida colonization (8.40%) among cat owners. This stands in marked contrast to higher isolation rates reported in other populations: 68% for C. albicans and 2% for C. glabrata in dental patients in Libya (Logien, 2022), 30% for C. albicans in periodontal cases (Khadim and Alfayyadh, 2025), and general population rates of 24.2% (Alizadeh et al., 2021) to 56.86% (Al-Qaysi and AL-Rubaie, 2024). This variability in Candida recovery is well documented in the literature. For instance, Mun et al. (2016) reported an oral yeast carriage rate of 48.3% in healthy adults, noting no significant difference from denture wearers. Such discrepancies likely reflect differences in study populations, underlying health conditions, and local oral ecology. Consistent with previous reports, approximately 10% of oral commensal yeast species can transition to opportunistic pathogens, causing conditions such as oral candidiasis (Pinto-Almazán et al., 2022; Sardi et al., 2013). Sociodemographic factorsa) Age groupThe present study identified a notably low prevalence of oral Candida colonization (1.68%) across several age cohorts (31–35, 46–50, and 51–55 years). This finding contrasts sharply with reports (Fukatsu et al., 2022) documented a 70% isolation rate in Japanese adults aged 40–49 years. Species-specific colonization also demonstrated age-associated patterns. Candida albicans was primarily isolated from the 31 to 35-year cohort (1.68%), whereas C. glabrata was mainly recovered from the 46 to 50 year group (1.68%). A significant correlation was observed between age and Candida isolation, aligning with studies from Jordan (Darwazeh et al., 2010), Iraq (Waheeb et al., 2023), and Poland (Loster et al., 2016). However, this finding diverges from that of a Libyan study (Logien, 2022), which reported no significant age-related correlation. The discrepancy in results across studies is likely attributable to confounding variables, such as oral hygiene practices, study design and objectives, and the presence of local predisposing factors, such as dental caries. b) SexIn the present study, 5.88% of Candida species were isolated from the oral cavity of female cat owners, compared to 2.52% in males. A sex-based analysis at the species level revealed that C. albicans was isolated equally from both sexes (1.68% each), whereas C. glabrata was predominantly recovered from females (4.20%). No significant difference or correlation between sex and the overall isolation of Candida was recorded. This absence of a significant sex-based association is consistent with the findings of several previous studies. Research from Portugal (Gerós-Mesquita et al., 2020)and Jordan (Darwazeh et al., 2010) found no significant link between sex and oral Candida carriage. A 2024 study (Al-Qaysi and AL-Rubaie, 2024) found a higher prevalence of C. albicans and C. glabrata in females, yet also concluded that this difference was not statistically significant. Conversely, the current findings conflict with those of other reports. Loster et al. (2016) documented a statistically significantly higher isolation rate of C. albicans from females (62.2%) than from males (52.4%). Another study (Abdulwadood and Al-Dahan, 2015) identified a significant inverse correlation in a specific clinical subgroup of patients using inhaled steroids. c) Economic statusThe current investigation found no significant association between economic status and the isolation of Candida species from cat owners’ oral cavity. This finding contrasts with the established literature, such as the study by Xiao et al. (2019), which reported a significant effect of socioeconomic status on Candida colonization. The link between lower socioeconomic status and increased risk of oral candidiasis is well-documented and is typically mediated through the following indirect pathways: 1) Compromised oral hygiene: Limited access to dental care and health education can lead to poorer oral hygiene practices, creating a favorable environment for Candida overgrowth (Patel, 2022). 2) Oral disease prevalence: Higher rates of untreated dental caries and tooth decay in disadvantaged populations can disrupt the oral microbiome and promote yeast colonization (Prachayakul et al., 2025). 3) Healthcare barriers: Financial constraints often prevent regular dental check-ups and treatments, allowing underlying oral health issues to persist and worsen (Albandar, 2024). 4) Systemic health disparities: Socioeconomic factors are linked to a higher prevalence of conditions such as diabetes, which impair immunity and increase susceptibility to fungal infections (Khan et al., 2023). The absence of this expected correlation in the present study cohort may be attributed to the specific demographics of cat owners, which could represent a population with a more homogenized socioeconomic profile or where pet ownership itself introduces confounding protective factors that mitigate the typical socioeconomic influences on oral health. d) EmploymentNo link was found between employment status and oral Candida in cat owners. This contrasts with the existing literature: (Xiao et al., 2019) employment type (an economic indicator) with colonization, while (Madero-Cabib and Reyes, 2022) that unemployment or precarious work (e.g., freelancing) increases oral health risks. They argue that low wages and irregular hours in such jobs lead to poor oral hygiene and diet, indirectly promoting various oral problems, such as multiple cavities, denture stomatitis, and periodontitis with Candida infection. e) SmokingThe current study observed a higher frequency of oral Candida isolation in non-smoking cat owners (5.04%) than in smokers (1.68%), with both C. albicans and C. glabrata isolated at equal rates (1.68%) among smokers. However, no significant difference or correlation was found between smoking status and oral Candida colonization. This finding aligns with studies from Japan (Sato et al., 2017) and Portugal (Gerós-Mesquita et al., 2020), which similarly reported no significant association. Conversely, it contrasts with research from Libya (Logien, 2022) that found a significantly higher colonization rate in smokers (18.1%). The scientific literature presents conflicting evidence on this relationship. While some studies have reported no increase in colonization among healthy smokers (Al-Dwairi et al., 2010), others have indicated that tobacco use elevates colonization levels (Muzurovic et al., 2013; Sheth et al., 2016), with smokers having a sevenfold higher likelihood of harboring oral Candida (Patel, 2022) recent review ( Zahra et al., 2025) found that the prevalence of oral candidiasis was approximately three times higher in active smokers, possibly due to smoking-induced reduction in salivary flow rate and subsequent decrease in salivary pH, which may promote the growth of C. albicans. This discrepancy suggests that multiple interacting factors beyond smoking status influence Candida colonization, including intimate contact-mediated microbial exchange and tobacco’s immunosuppressive properties (Mun et al., 2016; Rivera et al., 2019), which may synergistically affect colonization patterns in complex ways. Using the oral brushThis study demonstrated a significant negative correlation, confirming that less frequent tooth brushing increases the isolation of oral Candida in cat owners. The highest prevalence (4.20%) was found in individuals brushing only once daily. The results of this study are consistent with established research (Darwazeh et al., 2010; Muzurovic et al., 2012; Zahra et al., 2025), which links poor oral hygiene to higher Candida colonization and diversity. Species distribution varied with brushing habit: C. albicans was isolated from 3.36% of the once-daily brushing group, whereas C. glabrata was found in 3.36% of those brushing less than once daily. The role of toothpaste is complex. While its proper use reflects good oral hygiene that suppresses Candida, its effectiveness is formulation-dependent. Many toothpastes contain antimicrobial agents (e.g., bisbiguanides, herbal extracts) that can inhibit C. albicans, but their efficacy relies on consistent use as part of a thorough oral care routine (Nayak et al., 2010; Adwan et al., 2012; Patel, 2022). Environmental factorsSeasonCandida was frequently isolated from the oral cavities of cat owners in spring and summer, but with no significant seasonal correlation. This contrasts with (Di Carlo et al., 2025), who reported a significant peak of C. glabrata in autumn. Candida albicans was the most frequent species in most seasons, whereas C. glabrata and C. parapsilosis were more common in the spring. According to (Ma et al., 2025), such seasonal variability is driven by environmental factors such as temperature and humidity, which impact the growth and virulence of oral fungi and are intertwined with host factors such as immunity and dietary habits. Health-related variablesa) Administration of antibioticsThe current study identified a strong correlation between the use of oral antibiotics and increased isolation of Candida species from cat owners. Colonization was significantly higher in individuals using antibiotics (7.56%) than in those who were not (0.84%). Among the antibiotic users, C. glabrata was the predominant species isolated (5.04%), followed by C. albicans (2.52%). This finding aligns with the established literature, where prolonged antibiotic therapy is recognized as a critical risk factor for oral candidiasis. As noted by Patel (2022), antibiotics disrupt the normal bacterial flora that competitively inhibit fungal growth, thereby facilitating Candida overgrowth and its shift from commensalism to pathogenicity. The immune status of the host remains the primary determinant of Candida colonization. However, exposure to antimicrobial agents represents a major predisposing factor that can compromise this balance (Patel, 2022), when this is compromised, opportunistic colonization can occur (Fróis-Martins et al., 2024). Consequently, clinical strategies often focus on managing controllable risk factors—such as judicious antibiotic use—to reduce fungal burden and mitigate virulence, especially when direct enhancement of a patient’s immunological competence is not feasible. b) Wearing dentureContrary to established literature, the current study found a lower incidence of oral Candida in denture-wearing cat owners (0.84%) than in non-wearers (7.56%). Candida glabrata was also less frequent in denture-wearers (0.84% vs. 4.20% in non-wearers). The overall low frequency of isolation reflects good oral hygiene among the participants, and no correlation was found between denture use and the presence of Candida. This contrasts with the consensus that dentures are a significant risk factor for Candida infections (e.g., denture stomatitis), as they can act as a reservoir, allowing biofilm formation on the fitting surface create a warm, moist environment ideal for fungal growth and trap the fungus, especially with poor hygiene, continuous wear, or ill-fitting devices (Jaber, 2010; Logien, 2022; Manikandan et al., 2022; Patel, 2022; Zahra et al., 2025). c) Diabetes mellitusThe present study identified a significant inverse correlation between DM and oral Candida isolation in cat owners. This finding contrasts with some research (Xiao et al., 2019), which reported no significant difference in colonization between individuals with and without diabetes. However, our results align with the broader scientific consensus that DM substantially increases the risk of oral candidiasis. Hyperglycemia and impaired immune function primarily drive this elevated susceptibility. Elevated salivary glucose levels provide a favorable environment for Candida, leading to higher prevalence (>77% in patients with diabetes) and density of colonization compared with healthy individuals (approximately 48%) (Patel, 2022). This (Patel, 2022) association is well-supported. Studies by Amin et al. (2014), Zarei et al. (2022), and Al-Harba et al. (2024) have consistently reported more frequent and dense Candida carriage in individuals with diabetes, with C. albicans being the predominant species. Furthermore, factors such as poor glycemic control, longer disease duration, and the presence of oral prostheses significantly increase colonization risk and infection severity (Shenoy et al., 2014). d) Inhalation of steroidsIn the current study, only 0.84% of patients had positive growth for C. glabrata and received steroids, which is in line with that reported by Logien (2022) 1% of patients with dental problems receive oral corticosteroid therapy. The administration of corticosteroids—especially in topical or inhaled forms—has been associated with an elevated risk of oral Candida colonization. This occurs primarily through localized immunosuppression, which compromises key oral defense mechanisms, such as cellular immunity and phagocytic activity (Taylor et al., 2019). Corticosteroids disrupt the ecological balance within the oral cavity by dampening the host’s immune response, facilitating fungal adhesion, proliferation, and potential progression to symptomatic infection, such as oral candidiasis (Prachayakul et al., 2025). Several mechanisms have been proposed for corticosteroid-induced Candida colonization, such as local immunosuppression, in which corticosteroids inhibit inflammatory and immune pathways, reducing the capacity of oral mucosal tissues to resist fungal invasion (Lorraine and John, 2017) in Host–Microbe Dynamics: Immunosuppression alters the competitive relationship between the host and microbiota, favoring Candida overgrowth (Basmaciyan et al., 2019) corticosteroids causing enhanced fungal adhesion and proliferation: Suppression of host defenses provides a permissive environment for Candida species to adhere to epithelial surfaces and establish persistent colonies (Prachayakul et al., 2025). Candida and oral diseasesThis study found that while most cat owners (87.39%) were asymptomatic, Candida species were present in both healthy and symptomatic individuals. A significant statistical difference and an inverse correlation were observed between the presence of oral lesions and Candida isolation (p < 0.001). In asymptomatic individuals, C. albicans was detected in 2.52% and C. glabrata in 1.68%. In those with stomatitis (2.52%), C. albicans was found in 0.84% and C. glabrata in 1.68%. These findings align with the established understanding that Candida species are common commensals but can act as opportunistic pathogens (Akram et al., 2018; Alrabiah et al., 2019; Mokeem et al., 2019). The results agree with (Tata et al., 2019), who reported similar species-specific isolation from patients with stomatitis and gingivitis. This supports the model where Candida, as a normal part of the oral microbiome (Akram et al., 2018), can proliferate under conducive conditions such as poor oral hygiene, colonizing subgingival biofilms, and contributing to periodontal disease (Canabarro et al., 2013; Matic Petrovic et al., 2019). Detection of agglutinin-like sequence 1 and Candidalysin genes in C. albicans isolated from the oral cavity of cat owners The ALS1 virulence gene was present in all (4/4, 100%) C. albicans isolates from cat caregivers. This aligns with the established role of ALS1 as the most predominant and frequently expressed adhesin in the ALS gene family, which is critical for C. albicans pathogenicity (Tariq and Abbas, 2022). In the current study, the 100% detection rate is consistent with the gene’s known significance, but it is higher than frequencies reported in other studies, such as 69% in vulvovaginal candidiasis isolates (Hoyer et al., 2008) and 83% in vaginal isolates (Roudbary et al., 2012). Both the ALS1 adhesin gene and the ECE1 gene (encoding the Candidalysin toxin) were detected in 100% of C. albicans isolates from the oral cavity of cat caregivers, indicating a consistent expression of these key virulence determinants. The presence of ECE1 underscores the toxigenic potential of these isolates. However, the 100% ALS1 prevalence contrasts with some prior studies, such as (Ardehali et al., 2019) (92% in systemic isolates), though it aligns with others (Mohammed et al., 2017). These discrepancies may be due to differences in sample size, the intrinsic virulence of specific strains, or methodological variations in gene detection. This study detected the ECE1 gene, which encodes the Candidalysin toxin, in 100% of C. albicans isolates from cat caregivers, indicating a consistent expression of this pathogenic determinant among the studied population of cat owners. This prevalence is significantly higher than the 58.57% (41/70 isolates) reported by Al-Qaysi and AL-Rubaie (2024) in oral and respiratory tract specimens. Candida albicans virulence relies on mechanisms such as hyphal switching and enzyme secretion. Candidalysin is a cytolytic toxin encoded by the ECE1 gene that causes significant epithelial damage (Macias-Paz et al., 2023). ECE1 expression varies by strain and species and is not always dependent on hyphal formation. Al-Qaysi and AL-Rubaie (2024) confirmed the ECE1 gene in clinical isolates via a 435 bp PCR amplicon. The same study found a higher prevalence of ECE1 in male isolates (60%) than in female isolates (40%), indicating potential sex-based differences in virulence or colonization. ConclusionThis study reveals a low prevalence but high pathogenic potential of oral C. albicans in domestic cat owners, as evidenced by the universal presence of major virulence genes (ALS1, ECE1). While certain factors (older age, antibiotic drops, DM, oral lesions, and vitamin D3 deficiency) were linked to colonization risk, no association was found between commonly suspected risk factors. The universal presence of ALS1 and ECE1 highlights the pathogenic threat posed by these yeasts. This suggests that C. albicans colonizing the oral cavity of cat owners possesses a genetic profile linked to hyphal formation and tissue invasion, which could potentially increase its pathogenic capability. Limitations of the studyAlthough the study identified important and plausible associations, its primary limitations include its restricted and potentially underpowered sample of cat owners, the lack of critical confounding variables related to pet oral hygiene and degree of pet interaction, and the descriptive rather than functional nature of the virulence gene analysis. Recommendations for future researchThe results steer future research to the verification of causality based on longitudinal designs, the exploration of mechanisms (particularly regarding vitamin D3), and acceptance of a “One Health” perspective to see both sides—human-cat cycle transmission. The common presence of ASL1 and ECE1 genes warrants further functional molecular and chemical investigations of these virulence factors, particularly in the oral niche of cat owners. In the longer term, this work is intended to inform future evidence-based recommendations for oral health care management of pets and owners, especially in those with intrinsic risks. AcknowledgmentsWe thank everyone who helped facilitate the process of obtaining samples from cat owners and their understanding of the scientific feasibility of the research project. Conflict of interest No conflict of interest exists. Funding No funding agencies. Authors’ contributions Authors equally contributed. Data availability All required data were included in the text. ReferencesAdwan, G., Salameh, Y., Adwan, K. and Barakat, A. 2012. Assessment of antifungal activity of herbal and conventional toothpastes against clinical isolates of Candida albicans. Asian Pacific J. Trop. Biomed. 2(5), 375–379. Ahmad, N., Jafri, Z. and Khan, Z.H. 2020. Evaluation of nanomaterials to prevent oral Candidiasis in PMMA based denture wearing patients. A systematic analysis. J. Oral Biol. Craniofacial Res. 10(2), 189–193. Akram, Z., Al-Kheraif, A.A., Kellesarian, S.V., Vohra, F. and Javed, F. 2018. Comparison of oral Candida carriage in waterpipe smokers, cigarette smokers, and non-smokers. J. Oral Sci. 60(1), 115–120. Albandar, J.M. 2024. Disparities and social determinants of periodontal diseases. Periodontology 2000 2025(98), 125–137. Al-Dwairi, Z.N., Darwazeh, A.M.G., Al-Zwairi, A.A. and -W. 2010. The relationship between tobacco smoking and oral colonization with Candida Species. J. Contemp. Dent. Pract. 11(3), 17–24. Al-Ezzy, A.I.A. 2018. Immunopathological and modulatory effects of Cag A+ Genotype on gastric mucosa, inflammatory response, pepsinogens, and Gastrin-17 Secretion in Iraqi Patients infected with H. pylori. oamjms 6(5), 794. Al-Ezzy, A.I.A., Hameed, M.S., Jalil, W.I. and Mohamad, W.M. 2016. Pathophysiological effects of Vitamin C and E-Selenium combination on lipid profile and serum glucose of experimentally induced Sodium Nitrate Intoxication in Mice. RJPBCS 7(2), 958–964. Al-Harba, H.R., Nasir-Alla, N. and Jabir, A.A. 2024. The correlation between oral Candida albicans and Interlukine-23 in Diabetic Patients in Hilla City, Iraq. Med. J. Babylon 21(4), 915–920. Al-Khalidi, A.A.H., Al-Ezzy, A.I.A., hameed, M.S. and khamas, E.J. 2018. Correlation Between Aspergillosis and Renal Function Profile Analysis in Broilers of Diyala Province - Iraq. Diyala J. Agricult. Sci. 10 , 177–193. Al-Khalidi , A.A.H., Hameed, M.S. and Ali Ibrahim Ali Al-Ezzy. 2020. Effects Of Saccharomyces cerevisiae As Probiotic On Blood Indices, Humoral Immunity and Performance Of Isa Brown Laying Hens In Diyala Province-Iraq. Biochem. Cell. Arch. 20(1) , 2727–2733. Alizadeh, V., Hashemi, S.J., Rafat, Z., Daie-Ghazvini, R., Rezaie, S., Golipoor, Z. and Sharafkhah, M. 2021. Isolation of Candida species on human mucosal surfaces. New Zealand J. Med. Lab. Sci. 75(1), 33–37. Alkhuwailidy, H.A.M. and Alrufae, M.M. 2022. DNA sequencing of novel yeast isolated from bloodstream infections in Al-Najaf Province. Wiad. Lek. 75(4), 774–780. Alrabiah, M., Alshagroud, R.S., Alsahhaf, A., Almojaly, S.A., Abduljabbar, T. and Javed, F. 2019. Presence of Candida species in the subgingival oral biofilm of patients with peri-implantitis. Clin. Implant. Dentistry. Rel. Res. 21(4), 781–785. Amin, A., Sadiq, N. and Saeed, C. 2014. Isolation of Candida albicans from oral cavity of type II diabetic subjects and its relationship to total and differential white blood cell count. Zanco J. Med. Sci. (Zanco. J. Med. Sci). 18(3), 833–838. Ardehali, S.H., Azimi, T., Fallah, F., Aghamohammadi, N., Alimehr, S., Karimi, A.M. and Azimi, L. 2019. Molecular detection of ALS1, ALS3, HWP1 and SAP4 genes in Candida Genus isolated from hospitalized patients in Intensive Care Unit, Tehran, Iran. Cell. Mol. Biol. 65(4), 15–22. Basmaciyan, L., Bon, F., Paradis, T., Lapaquette, P. and Dalle, F. 2019. Candida albicans interactions with the host: crossing the intestinal epithelial barrier. Tissue Barriers 7(2), 1612661. Bhosale, A., Borde Dhande, M., V. Shinde, A. and Jadhav, P. 2023. Oral Candidiasis Review: pathogenesis, Clinical Presentation, And Treatment Strategies. J. Adv. Zool. 44 , 260–268. Calderone, R.A. and Clancy, C.J. 2012. Candida and candidiasis. Eds., In Calderone, R.A. and Clancy, C.J. 2nd ed.). Washington, American Society for Microbiology Press. Canabarro, A., Valle, C., Farias, M.R., Santos, F.B., Lazera, M. and Wanke, B. 2013. Association of subgingival colonization of Candida albicans and other yeasts with severity of chronic periodontitis. J. Periodontal. Res. 48(4), 428–432. Carroll. and Pfaller. 2024. Manual of Clinical Microbiology, 4 Volume Set. Washington, John Wiley & Sons. Dąbrowska, M., Sienkiewicz, M., Kwiatkowski, P. and Dąbrowski, M. 2018. Diagnosis and treatment of mucosa Candida spp. infections -a review article. Ann. Univ. Mariae Curie-Sklodowska, Sectio C -Biologia 73(1), 61 -68. Darwazeh, A.M., Hammad, M.M. and Al-Jamaei, A.A. 2010. The relationship between oral hygiene and oral colonization with Candida species in healthy adult subjects. Int. J. Dental Hygiene 8(2), 128–133. Di Carlo, P., Serra, N., Collotta, O., Colomba, C., Firenze, A., Aprea, L., Distefano, S.A., Cortegiani, A., Giammanco, G., Fasciana, T.M.A., Virruso, R., Capuano, A., Sergi, C.M. and Cascio, A. 2025. The Influence of the Seasonal Variability of Candida spp. Bloodstream Infections and Antifungal Treatment: a Mediterranean Pilot Study. Antibiotics 14(5), 452. Edelmann, A., Krüger, M. and Schmid, J. 2005. Genetic relationship between human and animal isolates of Candida albicans. J. Clin. Microbiol. 43(12), 6164–6166. Ellis, D.H., Davis, S., Alexiou, H., Handke, R. and Bartley, R. 2007. Descriptions of medical fungi. Australia: University of Adelaide Adelaide, Vol. 2. Fróis-Martins, R., Lagler, J. and Leibundgut-Landmann, S. 2024. Candida albicans Virulence Traits in Commensalism and Disease. Curr. Clin. Microbiol. Rep. 11(4), 231–240. Fukatsu, A., Tsuzukibashi, O., Fuchigami, M., Uchibori, S., Komine, C., Umezawa, K. and Wakami, M. 2022. Study on the Distribution at Species Level of Genus Candida in Human Oral Cavities, Using Culture and Multiplex PCR Methods. Open. J. Stomatology. 12(4), 119–129. Gerós-Mesquita, A., Carvalho-Pereira, J., Franco-Duarte, R., Alves, A., Gerós, H., Pais, C. and Sampaio, P. 2020. Oral Candida albicans colonization in healthy individuals: prevalence, genotypic diversity, stability along time and transmissibility. J. Oral Microbiol. 12(1), 1820292. Hall, G.S. 2013. Bailey & Scott’s diagnostic microbiology (13th ed.). Chicago, IL: American Society for Clinical Pathology. Hadi, R.M., Al-Ezzy, A.I.A. and Al-Zuhairi, A.H.K. 2025. Molecular detection of Aspergillus niger Genes NIG1, CMDA and mycotoxin genes Fum1, Pks from otomycosis among breeders of domestic cats with special Emphasis to risk factors In Diyala Governorate, Iraq. Assiut Vet. Med. J. 71(185), 1–21. Hameed, M.S. and Ali Al-ezzy, A.I. 2024. Evaluation of Antioxidant, Nephroprotective and Immunomodulatory Activity of Vitamins C and E -Sodium Selenite in Mice Intoxicated with Sodium Nitrate. Adv. Anim. Vet. Sci. 12(6), 1018–1027. Hameed, M.S., Al Zubaidi, R.M.H. and Al-Ezzy, A.I.A. 2024. Effectiveness of aqueous versus alcoholic extracts of Melia azedarach in amelioration of lipid profile, liver enzymes and innate inflammatory indices for white New Zealand rabbits. Adv. Anim. Vet. Sci. 12(7), 1256–1265. Hashemi, S.E., Shokohi, T., Abastabar, M., Aslani, N., Ghadamzadeh, M. and Haghani, I. 2019. Species distribution and susceptibility profiles of Candida species isolated from vulvovaginal candidiasis, emergence of C. lusitaniae. Curr. Med. Mycology 5(4), 26. Hoyer, L.L., Green, C.B., Oh, S.H. and Zhao, X. 2008. Discovering the secrets of the Candida albicans agglutinin-like sequence (ALS) gene family–a sticky pursuit. Med. Mycology 46(1), 1–15. Inci, M., Atalay, M.A., Özer, B., Evirgen, O., Duran, N., Motor, V.K., Koç, A.N., Önlen, Y., Kilinç, C. and Durmaz, S. 2013. Investigations of ALS1 and HWP1 genes in clinical isolates of Candida albicans. Turkish. J. Med. Sci. 43(1), 125–130. Jaber, D.A.J. 2010. Fungal Infection Associated with denture. Mustansiria. Dental. J. 7(2), 263–271. Jafar. 2021. Candidiasis Types, Causative Agents, and Treatment Methods. Sci. J. Medi. Res. 5(19), 90–93. Kaur, R., Dhakad, M., Goyal, R., Haque, A. and Mukhopadhyay, G. 2016. Identification and antifungal susceptibility testing of Candida species: a comparison of Vitek-2 system with conventional and molecular methods. J. Global. Infect. Dis. 8(4), 139–146. Khadim, A.A. and Alfayyadh, I. 2025. Investigation of virulence determinants of Candida species and some serological assessments of periodontitis in Thi-Qar Province, Iraq. Microbial Biosystems 10(2), 275–282. Khan, I., Ahmedi, S., Ahmad, T., Rizvi, M.M.A. and Manzoor, N. 2023. Incidence and prevalence of oral Candidal colonization in patients with cleft lip and palate. Nat. J. Maxillofacial. Surg. 14(1), 72–78. Lemberg, C., Martinez De San Vicente, K., Fróis-Martins, R., Altmeier, S., Tran, V.D.T., Mertens, S., Amorim-Vaz, S., Rai, L.S., D’Enfert, C., Pagni, M., Sanglard, D. and Leibundgut-Landmann, S. 2022. Candida albicans commensalism in the oral mucosa is favoured by limited virulence and metabolic adaptation. PLos Pathogens. 18(4), e1010012. Li, J., Vinh, D.C., Casanova, J.L. and Puel, A. 2017. Inborn errors of immunity underlying fungal diseases in otherwise healthy individuals. Curr. Opinion. Microbiol. 40, 46–57. Logien, S.M. 2022. Oral Candida carriage and fungi species prevalence Benghazi University]. Lorraine, I. and John, A. 2017. Physiologic and pharmacologic effects of corticosteroids. In: Holland-Frei Cancer Medicine. Eds., Bast, J.R.C., Croce, C.M., Hait, W.N., Hong, W.K., Kufe, D.W., Piccart-Gebhart, M., Pollock, R.E., Weichselbaum, R.R. and Wang, J.F.H.H. Washington, John Wiley & Sons, Vol. 1, pp: 34–67. Loster, J.E., Wieczorek, A. and Loster, B.W. 2016. Correlation between age and gender in Candida species infections of complete denture wearers: a retrospective analysis. Clin. Interventions Aging 1707, 1707–1714. Ma, X., Zeng, X., Huang, Z., Li, G., Liu, R., Luo, R., Li, X., Ling, S., Wang, C. and Gu, Y. 2025. Analysis of fungal microbiota diversity and potential pathogenic fungi in oral secretions and gut feces of captive giant pandas. Front. Microbiol. 16, 1522289. Macias-Paz, I.U., Pérez-Hernández, S., Tavera-Tapia, A., Luna-Arias, J.P., Guerra-Cárdenas, J.E. and Reyna-Beltrán, E. 2023. Candida albicans the main opportunistic pathogenic fungus in humans. Revista Argentina De Microbiología 55(2), 189–198. Madero-Cabib, I. and Reyes, C. 2022. Employment trajectories across the life course and oral health among older persons in a developing country. J. Appl. Gerontology 41(5), 1397–1406. Manikandan, S., Vinesh, E., Selvi, D.T., Kannan, R.K., Jayakumar, A. and Dinakaran, J. 2022. Prevalence of Candida among denture wearers and nondenture wearers. J. Pharm. BioAllied. Sci. 14(Suppl 1), S702–S705. Marcos-Arias, C., Eraso, E., Madariaga, L., Aguirre, J.M. and Quindós, G. 2011. Phospholipase and proteinase activities of Candida isolates from denture wearers. Mycoses 54(4), e10–e16. Marsh, P. and Martin, M. 2009. Oral fungal infections. Edinburgh, UK: Churchill Livingstone, pp: 166–179. Matic Petrovic, S., Radunovic, M., Barac, M., Kuzmanovic Pficer, J., Pavlica, D., Arsic Arsenijevic, V. and Pucar, A. 2019. Subgingival areas as potential reservoirs of different Candida spp in type 2 diabetes patients and healthy subjects. PLos One 14(1), e0210527. Mcmanus, B.A. and Coleman, D.C. 2014. Molecular epidemiology, phylogeny and evolution of Candida albicans. Infection. Genet. Evol. 21, 166–178. Mohammed, N.A., Ajah, H.A. and Abdulbaqi, N.J. 2017. Detection the prevalence of adhesins and extracellular hydrolytic enzymes genes in Candida albicans biofilm formation. Iraqi J. Sci. 1000, 988–1000. Mokeem, S.A., Abduljabbar, T., Al-Kheraif, A.A., Alasqah, M.N., Michelogiannakis, D., Samaranayake, L.P. and Javed, F. 2019. Oral Candida carriage among cigarette-and waterpipe-smokers, and electronic cigarette users. Oral Dis. 25(1), 319–326. Muayad Hadi, R. and Hanash Khlaf Al-zuhairi, A. 2025. Phenotypic Identification and Molecular Characterization of Aspergillus Niger, Fumonisin and Ochratoxin Genes from Otomycosis in Domestic Cats with Special Emphasis to Underlying Risk Factors. Diyala. J. For. Vet. Sci. 3(1), 120–141. Muayad, H.R., Ali, A.E.,.A.I. and Khlaf, A.Z.A.H. 2025. Molecular Detection Of Aspergillus Niger Genes NIG1, CMDA And Mycotoxin Genes Fum1, Pks From Otomycosis Among Breeders Of Domestic Cats With Special Emphasis To Risk Factors In Diyala Governorate, Iraq. Assiut Vet. Med. J. 71(185), G1–21. Mun, M., Yap, T., Alnuaimi, A., Adams, G. and Mccullough, M. 2016. Oral Candidal carriage in asymptomatic patients. Austral. Dental J. 61(2), 190–195. Musleh, T. and Al-Saadi, H.A.M. 2022. Diagnosis of yeasts isolated from the oral cavity and groin area in children of Kirkuk city/Iraq. Tikrit J. Pure Sci. 27(4), 7–16. Muzurovic, S., Babajic, E., Masic, T., Smajic, R. and Selmanagic, A. 2012. The relationship between oral hygiene and oral colonisation with Candida species. Med. Arch. 66(6), 415–417. Muzurovic, S., Hukic, M., Babajic, E. and Smajic, R. 2013. The relationship between cigarette smoking and oral colonization with Candida species in healthy adult subjects. Med. Glas. (Zenica). 10(2), 397–399. Nayak, A., Nayak, R.N. and Bhat, K. 2010. Antifungal activity of a toothpaste containing Ganoderma lucidum against Candida albicans-an in vitro study. J. Int. Oral Health 2(2), 51–57. New England Biolabs. 2024. Protocol for OneTaq® Quick-Load 2X Master Mix with Standard Buffer (M0486). https://www.neb.com/en/protocols/2012/09/11/protocol-for-onetaq-quick-load-2x-master-mix-with-standard-buffer-m0486 Nikaein, D., Shirani, D., Sharifzadeh, A., Alavi, A., Khosravi, A.R.J.V.M. and Science. 2023. Antifungal susceptibility profile of yeasts isolated from the oral cavity of cats. J. V. M. 9(6), 2414–2419. Patel, M. 2022. Oral cavity and Candida albicans: colonisation to the development of infection. Pathogens 11(3), 335. Pinto-Almazán, R., Frías-De-León, M.G., Fuentes-Venado, C.E., Arenas, R., González-Gutiérrez, L., Chávez-Gutiérrez, E., Torres-Paez, O.U. and Martínez-Herrera, E. 2022. Frequency of Candida spp. in the oral cavity of asymptomatic preschool Mexican children and its association with nutritional status. Children 9(10), 1510. Prachayakul, A., Sucharitakul, J., Chadsiri, J. and Prapinjumrune, C. 2025. Salivary iron and Candida colonization in oral lichen planus patients undergoing topical steroid therapy. BMC Oral Health 25(1), 589. Rivera, R.E., Zuluaga, A., Arango, K., Kadar, I., Pinillos, P.A., Montes, L.F., Cepeda, E.C., González, E., Alfonso, P.A., Villalba, A.A., Casanova, L.F., Perez, A., Roa, A., Arias, M.J., Cuellar, J.O.F., Pedraza, L., Vasquez, A.A., Suarez, B.L., Gomez, B.L., Bedout, C.D. and Cano, L.E. 2019. Characterization of oral yeasts isolated from healthy individuals attended in different Colombian dental clinics. J. Biomed. Res. 33(5), 333. Ropars, J., Maufrais, C., Diogo, D., Marcet-Houben, M., Perin, A., Sertour, N., Mosca, K., Permal, E., Laval, G., Bouchier, C., Ma, L., Schwartz, K., Voelz, K., May, R.C., Poulain, J., Battail, C., Wincker, P., Borman, A.M., Chowdhary, A., Fan, S., Kim, S.H., Le Pape, P., Romeo, O., Shin, J.H., Gabaldon, T., Sherlock, G., Bougnoux, M.E. and D’Enfert, C. 2018. Gene flow contributes to diversification of the major fungal pathogen Candida albicans. Nature Commun. 9(1), 2253. Roudbary, M., Roudbarmohammadi, S., Bakhshi, B. and Farhadi, Z. 2012. Relation of ALS 1 and ALS3 genes and fluconazole resistance in Candida albicans isolated from vaginal Candidacies. Int. J. Mol. Clin. Microbiol. 2(2), 170–174. Sardi, J.C.O., Scorzoni, L., Bernardi, T., Fusco-Almeida, A.M. and Mendes Giannini, M.J.S. 2013. Candida species: current epidemiology, pathogenicity, biofilm formation, natural antifungal products and new therapeutic options. J. Med. Microbiol. 62(1), 10–24. Sato, T., Kishi, M., Suda, M., Sakata, K., Shimoda, H., Miura, H., Ogawa, A. and Kobayashi, S. 2017. Prevalence of Candida albicans and non-albicans on the tongue dorsa of elderly people living in a post-disaster area: a cross-sectional survey. BMC. Oral. Health. 17(1), 51. Sharon, V. and Fazel, N. 2010. Oral candidiasis and angular cheilitis. Dermatologic Therapy 23(3), 230–242. Shenoy, M., Puranik, R., Vanaki, S., Puranik, S., Shetty, P. and Shenoy, R. 2014. A comparative study of oral Candidal species carriage in patients with type1 and type2 diabetes mellitus. J. Oral Maxillofacial Pathol. 18(Suppl 1), S60–S65. Sheth, C.C., Makda, K., Dilmahomed, Z., González, R., Luzi, A., Jovani-Sancho, M.D.M. and Veses, V. 2016. Alcohol and tobacco consumption affect the oral carriage of Candida albicans and mutans streptococci. Lett. Appl. Microbiol. 63(4),254–259. Taiba Mansour Muhammad Musleh1. and Hadi Alwan Muhammad Al-Saadi. 2022. Diagnosis of yeasts isolated from the oral cavity and groin area in children of Kirkuk city/Iraq. Tikrit. J. Pure. Sci. 27(4), 7–16. Tariq, M.H.M. and Abbas, U.K. 2022. Molecular detection of agglutinin-like sequence 1 gene in Candida albicans that is isolated from diabetic foot patients. Mustansiriya. Med. J. 21(1), 72–77. Tata, W., Thepbundit, V., Kuansuwan, C. and Preechasuth, K. 2019. Distribution of Candida species in oral candidiasis patients: association between sites of isolation, ability to form biofilm, and susceptibility to antifungal drugs. J. Assoc. Med. Sci. 52(1), 1–7. Taylor, M., Brizuela, M., & Raja, A. (2019). Oral candidiasis. Vourc’h, G., Moutou, F., Morand, S. and Jourdain, E. 2022. Zoonoses: the ties that bind humans to animals (1st edition ed. Vol. 1). France Éditions Quae. Waheeb, E.H.A., Mohammed Hashim Al-Yasiri. and Afrah Abid Maktoof. 2023. The role of Candida species in the occurrence of dental caries in Thi Qar Governorate. Univ. Thi-Qar J. Sci. 10(1), 30–35. White, T.J., Bruns, T.D., Lee, S.B. and Taylor, J.W. 1990. Amplification and direct sequencing of fungal ribosomal RNA genes for phylogenetics. In: PCR protocols: a guide to methods and applications. Eds., Innis, MA., Gelfand, D.H., Sninsky, J.J. and White, T.J. New York, NY: Academic Press, Vol. 18, pp: 315 -322. Xiao, J., Fogarty, C., Wu, T.T., Alkhers, N., Zeng, Y., Thomas, M., Youssef, M., Wang, L., Cowen, L., Abdelsalam, H. and Nikitkova, A. 2019. Oral health and Candida carriage in socioeconomically disadvantaged US pregnant women. BMC. Pregnancy. Childbirth. 19(1), 480. Zahra, S.A., Ahmed, T., Hassan, W., Aslam, S., Javed, H., Ali, U. and Ghaffari, A. 2025. Oral Candidiasis Association with Dental Hygiene in Population of Islamabad-A Cross-Sectional Analysis. Mirpur J. Med. Sci. 3(1), 41–47. Zarei, N., Roudbary, M., Roudbar Mohammadi, S., Dos Santos, A.L., Nikoomanesh, F., Mohammadi, R., Shirvan, B.N. and Yaalimadad, S. 2022. Prevalence, molecular identification, and genotyping of Candida species recovered from oral cavity among patients with diabetes mellitus from Tehran, Iran. Adv. Biomed. Res. 11(1), 29. | ||
| How to Cite this Article |
| Pubmed Style Ali MA, Al-ezzy AIA. Investigating the human–animal interface: Clinical and molecular features of oral Candida spp. in cat owners. Open Vet. J.. 2026; 16(2): 1012-1026. doi:10.5455/OVJ.2026.v16.i2.22 Web Style Ali MA, Al-ezzy AIA. Investigating the human–animal interface: Clinical and molecular features of oral Candida spp. in cat owners. https://www.openveterinaryjournal.com/?mno=272272 [Access: February 27, 2026]. doi:10.5455/OVJ.2026.v16.i2.22 AMA (American Medical Association) Style Ali MA, Al-ezzy AIA. Investigating the human–animal interface: Clinical and molecular features of oral Candida spp. in cat owners. Open Vet. J.. 2026; 16(2): 1012-1026. doi:10.5455/OVJ.2026.v16.i2.22 Vancouver/ICMJE Style Ali MA, Al-ezzy AIA. Investigating the human–animal interface: Clinical and molecular features of oral Candida spp. in cat owners. Open Vet. J.. (2026), [cited February 27, 2026]; 16(2): 1012-1026. doi:10.5455/OVJ.2026.v16.i2.22 Harvard Style Ali, M. A. & Al-ezzy, . A. I. A. (2026) Investigating the human–animal interface: Clinical and molecular features of oral Candida spp. in cat owners. Open Vet. J., 16 (2), 1012-1026. doi:10.5455/OVJ.2026.v16.i2.22 Turabian Style Ali, Moamen Amer, and Ali Ibrahim Ali Al-ezzy. 2026. Investigating the human–animal interface: Clinical and molecular features of oral Candida spp. in cat owners. Open Veterinary Journal, 16 (2), 1012-1026. doi:10.5455/OVJ.2026.v16.i2.22 Chicago Style Ali, Moamen Amer, and Ali Ibrahim Ali Al-ezzy. "Investigating the human–animal interface: Clinical and molecular features of oral Candida spp. in cat owners." Open Veterinary Journal 16 (2026), 1012-1026. doi:10.5455/OVJ.2026.v16.i2.22 MLA (The Modern Language Association) Style Ali, Moamen Amer, and Ali Ibrahim Ali Al-ezzy. "Investigating the human–animal interface: Clinical and molecular features of oral Candida spp. in cat owners." Open Veterinary Journal 16.2 (2026), 1012-1026. Print. doi:10.5455/OVJ.2026.v16.i2.22 APA (American Psychological Association) Style Ali, M. A. & Al-ezzy, . A. I. A. (2026) Investigating the human–animal interface: Clinical and molecular features of oral Candida spp. in cat owners. Open Veterinary Journal, 16 (2), 1012-1026. doi:10.5455/OVJ.2026.v16.i2.22 |